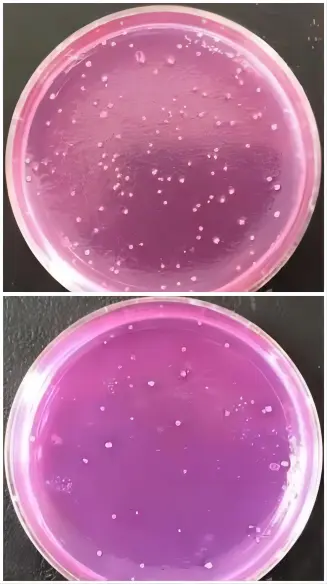
软琼脂集落形成实验

平板集落形成实验、软琼脂集落形成实验介绍
发布时间:2026-01-05 浏览次数:2145
细胞集落形成是检测培养细胞增殖能力的有效方法,通过计算集落形成率,来测定测试细胞的增殖能力。
实验前准备:6孔板、吸管、枪头、血球计数板、基质胶等放入超净工作台消毒30min。
1、平板集落形成实验(适用于贴壁细胞)
① 取出贴壁率 > 90%的细胞(处于对数生长期),消化离心,重悬细胞并进行细胞计数。
② 6孔板种板:实验分组,每个孔中加入1000个细胞,放入CO2培养箱培养。
③ 培养1周后,当肉眼可见集落形成时,取出6孔板,弃除培养液,每孔加入2mL甲醇固定30min,弃除甲醇,每孔加入2mL 0.1%结晶紫染色3min,然后清洗掉结晶紫,数码相机拍照,光镜下计数集落
结果如下:

2、软琼脂集落形成实验(适用于悬浮细胞)
1. 收集对数生长期的细胞进行活细胞计数,然后调整细胞浓度,用含20%FBS的DMEM制成1000活细胞/ml的细胞悬液。
2. 用蒸馏水制备1.2%、0.7%两个浓度的低熔点琼脂糖,高压灭菌后,维持在40℃不会凝固;
3. 1.2%琼脂糖和2xDMEM等体积混合,6孔板中加入1.4ml,RT凝固作为底层琼脂,置CO2温箱中备用;
4. 0.7%琼脂糖和2xDMEM等体积混合,再加入细胞悬液充分混匀,RT凝固作为上层琼脂,勿有气泡,将实验组和对照组分两组加好,盖上盖并作好标记。在室温放置20分钟使细胞琼脂悬液凝固。
5. 然后移培养板或平皿于CO2培养箱中37℃进行培养。
6. 培养7~10天,肉眼观察并计数细胞集落。
结果:
以肉眼可见的细胞团作为计数集落的标准。集落的计数和计算:集落数=n孔中细胞集落数总和/n孔,
集落形成率 = 集落数/接种培养细胞总数×100%
结果如下:
来源:“YuJinBio誉津医学”公众号,作者~Lisa。
说明:文章、视频、图片等所有内容,仅用于学习交流,若有侵权内容及其他涉法内容,请及时联系删除或修改,特此声明!










